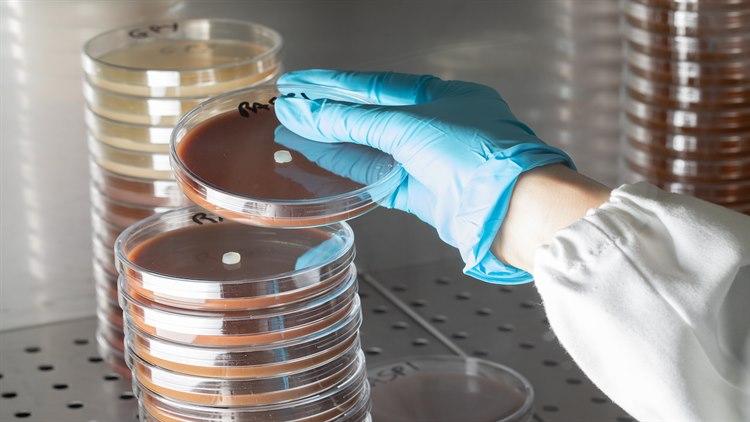
Stabler av petriskåler med soppkolonier.

Disse grønnsakene er sunnest om du koker dem
Noen grønnsaker er sunnest hvis de blir varmebehandlet. Her er en oversikt over hvilke.

Av:
Marthe Lein, journalist.
Sist oppdatert:
26. juli 2022
Artikkelen er mer enn to år gammel og kan inneholde utdatert informasjon
Ikke all mat er mest næringsrik når de spises rå. Noen grønnsaker er sunnest når de tilberedes.
Her er noen eksempler (oversikten er hentet fra Medical Daily1):
Asparges: Når asparges tilberedes, brytes celleveggene ned og næringsstoffer frigjøres. Dette gjør at vitamin A, B9, C og E blir mer tilgjengelig og lettere absorberes av kroppen.

Sopp: Sopp inneholder store mengder av antioksidantet ergothioneine. Dette frigjøres under matlaging.

Spinat: Dette er en grønnsak som er rik på næringsstoffer som jern, magnesium, kalsium og sink. Men næringsstoffene absorberes lettere når spinaten er tilberedt. Hvis spinaten varmes opp, blir bundet kalsium frigjort og blir mer tilgjengelig for kroppen.

Tomater: Den rødoransje fargen i tomater blir dannet av antiokidantet lykopen. Når tomatene behandles med varme, vil mer lykopen frigjøres. Varmen bidrar til å bryte ned de tykke celleveggene, som inneholder flere viktige næringsstoffer. Når tomatene kokes, vil C-vitamininnholdet bli lavere, men lykopeninnholdet vil altså øke betraktelig hvis tomatene varmebehandles i mer enn 30 minutter.

Gulrøtter: Kokte gulrøtter inneholder mer betakaroten enn rå gulrøtter. Betakaroten er et fettløselige vitamin som er bra for beinvekst, syn og immunsystemet. Koker du gulrøttene med skallet på, vil enda mer av næringsstoffene beholdes.

Paprika: Paprika er en stor kilde til antioksidanter, blant annet karotenoider, betakaroten og lutein. Varme bryter ned celleveggene, noe som gjør at næringsstoffene lettere tas opp i kroppen. På samme måte som tomater, vil vitamin C gå tapt når grønnsaken kokes. Prøv å steke dem i stedet.

Grønne bønner: Nivået av antioksidanter er mindre i grønne bønner hvis de blir kokt, og høyere hvis de bakes, tilberedes i mikrobølgeovn, blir grillet eller stekt.

Blomkål, brokkoli og rosenkål: Disse grønnsakene inneholder glukosinolater. Dette stoffet omdannes til en potent antioksidant kalt sulforafan når vi spiser disse grønnsakene. For at denne omdannelsen skal skje, må et enzym i disse grønnsakene kalt myrosinase være aktivt. Forskning har funnet at damping av disse grønnsakene bevarer både vitamin C og myrosinase.
- Medical Daily, Nine Vegetables That Are Healthier For You When Cooked, Laura Brown, 2022 www.medicaldaily.com